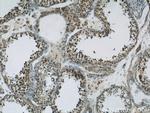
TBC1D1 Antibody in Immunohistochemistry (Paraffin) (IHC (P))
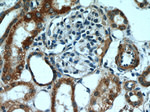
TBC1D1 Antibody in Immunohistochemistry (Paraffin) (IHC (P))

Search
Proteintech
TBC1D1 Polyclonal Antibody
{{$productOrderCtrl.translations['antibody.pdp.commerceCard.promotion.promotions']}}
{{$productOrderCtrl.translations['antibody.pdp.commerceCard.promotion.viewpromo']}}
{{$productOrderCtrl.translations['antibody.pdp.commerceCard.promotion.promocode']}}: {{promo.promoCode}} {{promo.promoTitle}} {{promo.promoDescription}}. {{$productOrderCtrl.translations['antibody.pdp.commerceCard.promotion.learnmore']}}
产品信息
22124-1-AP
种属反应
已发表种属
宿主/亚型
分类
类型
抗原
偶联物
形式
浓度
规格
纯化类型
保存液
内含物
保存条件
运输条件
产品详细信息
Immunogen sequence: LAEQFHLKH QFPSKQQPKD VPYKELLKQL TSQQHAILID LGRTFPTHPY FSAQLGAGQL SLYNILKAYS LLDQEVGYCQ GLSFVAGILL LHMSEEEAFK MLKFLMFDMG LRKQYRPDMI ILQIQMYQLS RLLHDYHRDL YNHLEEHEIG PSLYAAPWFL TMFASQFPLG FVARVFDMIF LQGTEVIFKV ALSLLGSHKP LILQHENLET IVDFIKSTLP NLGLVQMEKT INQVFEMDIA KQLQAYEVEY HVLQEELIDS SPLSDNQRMD KLEKTNSSLR KQNLDLLEQL QVANGRIQSL EATIEKLLSS ESKLKQAMLT LELERSALLQ TVEELRRRSA EPSDREPECT QPEPTGD (813-1168 aa encoded by BC050321)
靶标信息
The product of this gene is a microtubule-associated protein that is predominantly expressed in cells of epithelial origin. Microtubule-associated proteins are thought to be involved in microtubule dynamics, which is essential for cell polarization and differentiation. This protein has been shown to be able to stabilize microtubules, and may serve to modulate microtubule functions. Studies of the related mouse protein also suggested an essential role in microtubule function required for spermatogenesis.
仅用于科研。不用于诊断过程。未经明确授权不得转售。
生物信息学
蛋白别名: TBC1 (tre-2/USP6, BUB2, cdc16) domain family, member 1; TBC1 domain family member 1; tre-2/USP6, BUB2, cdc16) domain family, member 1; unnamed protein product
基因别名: 1110062G02Rik; AI385682; AW555803; KIAA1108; mKIAA1108; TBC; TBC1; TBC1D1
UniProt ID: (Human) Q86TI0, (Mouse) Q60949
Entrez Gene ID: (Human) 23216, (Mouse) 57915